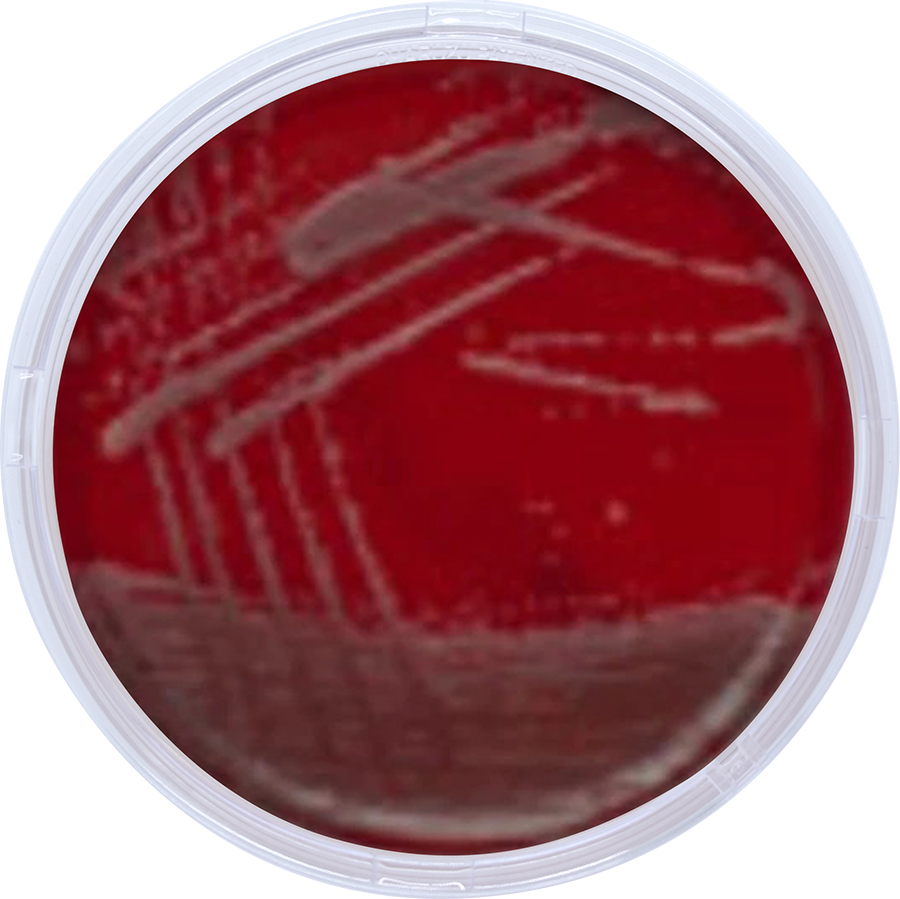

Agarin GS 900
Catalog Number : ABL-GS900
Agarind (Laboratorium Grade Agar Powder)ABL-GS900Gel Strength of > 950 g/cm2Mesh : 60 MicronMoisture... Read More
BLOOD AGAR BASE
Catalog Number : 912
BLOOD AGAR BASE is used for the isolation, cultivation and detection of hemolytic reaction of fastid... Read More
.png.png)
BRAIN HEART INFUSION AGAR
Catalog Number : B02
BRAIN HEART INFUSION AGAR is used for the cultivation of fastidious bacteria (streptococci, pnemococ... Read More

BRAIN HEART INFUSION BROTH
Catalog Number : B01
BRAIN HEART INFUSION BROTH (BHIB) is a liquid medium rich in nutrients, suitable for the cultivation... Read More

CANDIDA CHROMOGENIC AGAR
Catalog Number : 999
CANDIDA CHROMOGENIC AGAR is an alternative chromogenic formulation to the traditional media for the ... Read More

CHOCOLATE AGAR
Catalog Number : 913
GC AGAR BASE is used with various additives for the isolation and cultivation of pathogenic microorg... Read More

CLED AGAR
Catalog Number : 914
CLED AGAR is a non-selective diff erential plating medium for the growth and enumeration of urinary... Read More

E.COLI COLIFORM CHROMOGENIC AGAR
Catalog Number : 991
Solid, selective and differential culture medium for the detection and enumeration of total coliform... Read More